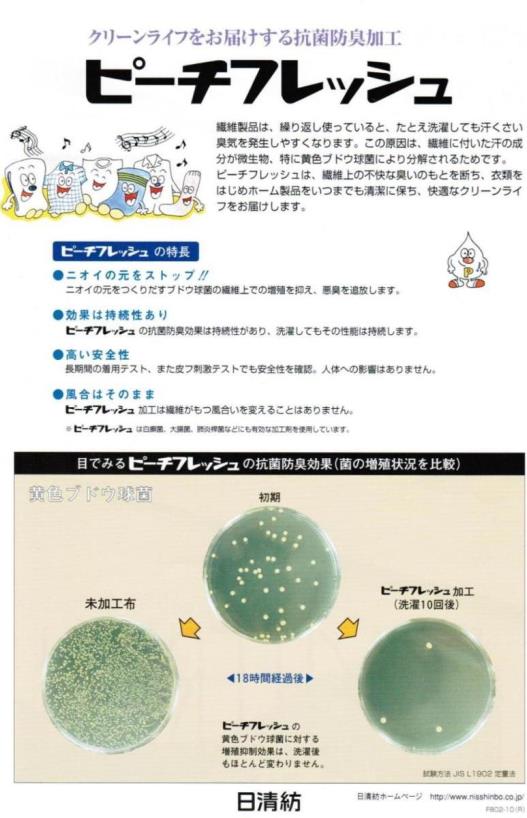

| サイズ表 (単位:cm) | ||||||
| サイズ | 衿回り | 半袖丈 | 肩幅 | 胸回り | 着丈 | |
| 140cmA体 | 33 | 20 | 37 | 88 | 56 | |
| 150cmA体 | 34 | 21 | 39 | 92 | 62 | |
| 155cmA体 | 35 | 22 | 41 | 96 | 66 | |
| 160cmA体 | 36 | 23 | 43 | 100 | 70 | |
| 165cmA体 | 37 | 24 | 45 | 104 | 73 | |
| 170cmA体 | 38 | 25 | 47 | 108 | 73 | |
| 175cmA体 | 39 | 25 | 48 | 111 | 75 | |
| 180cmA体 | 40 | 26 | 49 | 114 | 75 | |
| 185cmA体 | 41 | 26 | 50 | 117 | 77 | |
| 190cmA体 | 42 | 26 | 50 | 120 | 77 | |
| 160cmB体 | 40 | 23 | 47 | 117 | 71 | |
| 170cmB体 | 42 | 25 | 49 | 124 | 74 | |
| 180cmB体 | 44 | 26 | 51 | 132 | 77 | |
| 190cmB体 | 46 | 26 | 53 | 140 | 80 | |